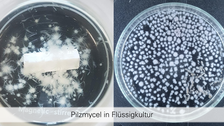
AG Enzymtechnik

Bioprocesses
Bioprocess technology
The Bioprocess Technology research group investigates the behavior of microorganisms in the technical environment of the bioreactor. The aim is to obtain the information required for the development of biotechnological production processes. In detail, this involves determining the kinetics of bioreactions and characterizing transport processes. An important method here is data analysis and balancing of the processes using mathematical models.

© Schmidt

© Schmidt

© Haas

© Schneider

© Schneider

© Schneider
A particular focus of the research group is on the utilization of the metabolic capacity of yeasts. The formation of ethyl acetate from whey with Kluyveromyces marxianus and pheromone-based communication in Saccharomyces cerevisiae are currently being investigated.
Projects of the Bioprocess Engineering research group:
- EtAcMem - Production of ethyl acetate from whey residues with Kluyveromyces marxianus and product recovery using membrane processes
- LEMON - Integrated two-stage fermentation process for the development of biorefineries utilizing residual materials using the example of citric acid production
- VOLATIL - Integrated two-stage fermentation processes for the utilization of waste streams in biorefineries
- Yeast pheromones for the control of biotechnological processes (HeSPro)
Research group leader:
 © Mann
© Mann
Private lecturer
NamePD Dr.-Ing. habil. Christian Löser
Head of Bioprocess engineering
Send encrypted email via the SecureMail portal (for TUD external users only).
Enzyme Technology
Enzymes - versatile biological catalysts, without which there would be no life in this world - these are the building blocks we deal with in the "Enzyme Technology" research group. We follow the entire workflow from the screening of various enzyme producers, through production and purification, to characterization and application development. Basidiomycetes, also known as stalk fungi, play a particularly important role here. These have an extraordinary enzyme spectrum whose potential must be exploited. In nature, these fungi mainly use their enzymes to break down organic substances and thus to extract nutrients. However, the same degradation mechanisms can also be used in white biotechnology. For example, cellulases and xylanases can be used to break down lignocellulosic materials, usually residues from other industries, into their monomers and use them as new starting materials for various biological or chemical conversions into high-quality chemicals. Other important enzymes in our research are the so-called laccases, which in nature are involved in the degradation of lignin and are able to break down structurally similar xenobiotics such as toxins, dyes, hormones, etc. This opens up a huge range of applications for the degradation of lignin. This opens up a huge range of applications from wastewater treatment and soil remediation to textile finishing and use in cosmetics. We mainly produce these enzymes using solid-state fermentation - a cultivation method that comes very close to the natural habitat of these fungi. The extensive monitoring and modelling of these complex processes is another research focus of our group, as is the continuous development of suitable immobilization strategies, highly sensitive biosensor systems, various characterization methods, including the use of special microfluidics and the production of other interesting ingredients such as flavourings and dyes. The incredible diversity of these fungi enables varied and interdisciplinary fields of work, which are reflected in our research group. Since 2018, mycelium-based composites (MBC) have also been investigated and developed as biodegradable alternatives for petroleum-based materials and building components. The incredible diversity in the realm of fungi enables varied and interdisciplinary fields of work, which are reflected in our research group.

© AG Enzymtechnik

© AG Enzymtechnik

© AG Enzymtechnik

© AG Enzymtechnik

© AG Enzymtechnik

© AG Enzymtechnik
Core research areas:
- Solid matter fermentation incl. monitoring
- Enzyme production, especially laccases
- Dye production
- Enzyme characterization
- biosensor technology
- Enzyme immobilization
- Mycelium-based materials
With the following project focuses:
- Analyses for the cultivation and quantification of basidiomycetes and their enzymes
- Development of technologies and processes for the cultivation of dye-producing fungi and for the extraction of natural dyes
-
Development of technologies and processes for the production of environmentally friendly mycelium-based materials
- Remediation of soil and water using enzymes and basidiomycetes
Projects of the Enzyme Technology research group:
- POET - Development of an efficient biotechnological production process for the sustainable chromophore xylindein with multifunctional use in finishing technology
- MycoMatrix - Sustainable building system from fungal mycelium
- FungiScout: The hidden kingdom: discovering fungi for food, clothing, warmth and light
- FungiColor - Natural dyes from basidiomycota fungi
- CrossCat symbiosis of biological & chemical catalysts for the sustainable conversion of hemicelluloses
- Development of technologies and processes for the cultivation of dye-producing fungi and for the extraction of natural dyes.
- Symbiosis of catalysis and biotechnology for the sustainable utilization of hemicelluloses in biorefineries
- ZMWBioKat: Metallic foams in biosensors
 © TUD
© TUD
Project researcher
NameDr.-Ing. Anett Werner
Head of enzyme technology
Send encrypted email via the SecureMail portal (for TUD external users only).
Plant and algae biotechnology
Background:
Against the background of the increasing scarcity of fossil raw materials, rising population density in developing and emerging countries on the one hand and demographic change in industrialized nations on the other, modern biotechnological production processes for the sustainable production of active ingredients and additives for the pharmaceutical, cosmetics or food industries are increasingly becoming the focus of research and development. Plants and algae reveal a broad spectrum of nutritionally and pharmaceutically relevant ingredients.
Traditional methods of producing active ingredients, e.g. chemical synthesis or extraction from plant material, have several disadvantages. For example, product quality and quantity are subject to strong fluctuations due to numerous biotic and abiotic influencing factors. Chemical synthesis produces a large number of undesirable by-products that have to be laboriously separated from the target product. In addition, only a few chemical representations exhibit natural bioactivity. In-vitro processes, on the other hand, enable GMP-compliant, continuous production under optimized conditions and with consistent quality and quantity.

© Haas

© Schott

© Schott

© Schott

© Schott

© Lassig
Core research areas:
The Algae and Plant Biotechnology research group has been working for many years on the development of efficient processes for the production of active ingredients using plant cell cultures, hairy roots and micro- and macroalgae. In addition to the induction and screening of suitable cell lines, expertise lies primarily in the areas of
- Natural product analysis (HPLC, GC, GC/MS)
- (Photo-) bioreactor design(scale-up and scale-down)
- Online monitoring of heterogeneous biotechnological systems (e.g. respiratory activity and laser-optical sensors)
- Process optimization (process control, elicitation)
- Downstream processing
- Green bioprinting
Projects Research Group Plant and Algae Biotechnology:
-
Simulation of radiation conditions in horizontal tubular photobioreactors
- MOProAlge: Rapid monitoring system for optimizing process control for the production of active ingredients with microalgae
- SchuPlaHolz - Biobased protective agent from plant cell culture for wood-based materials
- Algae4Cycle - Modular on-site plant for the algae-based treatment of process wastewater
-
Model-based continuous cultivation of the cyanobacterium Arthrospira platensis on a technical scale
-
Green Bioprinting - Novel agglomeration environment for plant cells
- MIPHO multispectral bioreactor for phototrophic organisms
- BioSpeckle - Development of a laser-optical sensor system for non-invasive biomass determination in biotechnological processes
- New production system for plant secondary metabolites based on cell-free biocatalysis in a cascaded, compartmentalized hairy root reactor
All research projects of the Chair of Bioprocess Engineering
Research group leader:
 © Mann
© Mann
Scientist
NamePD Dr.-Ing. habil. Juliane Steingroewer
Head of Plant- and Algaebiotechnology
Send encrypted email via the SecureMail portal (for TUD external users only).